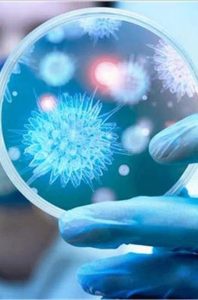

“كورونا” يفتح ملفات “الحروب البيولوجية”: لماذا تشير أصابعُ الاتّهام إلى الغرب؟
تأريخُ صراعات “الدول المتطورة” يتداخلُ مع كواليس الحاضر والمستقبل
المسيرة | ضرار الطيب
إن الحديثَ عن الارتباط بين ما يشهدُه العالَمُ اليومَ من انتشار مخيفٍ لوباء “كورونا”، وبين الحروب البيولوجية، ليس مُجَـرّد هَوَسٍ بنظرية المؤامرة، كما يحاول البعض إظهاره؛ لأَنَّ نظرة بسيطة على بعض محطات هذه الحروب خلال التأريخ كفيلة بأن تدهش أي إنسان بمدى العدوانية والوحشية التي وصلت إليه من تسمي نفسها “الدول العظمى” في هذا المجال والذي إن أدرجنا فيروس كورونا ضمن قائمة أسلحته، لن يكون الأمر مستغرباً أَو بعيداً عن السياق أبداً، وعلى العكس فَإنَّ توقيتَ انتشار هذا الفيروس اليوم وظروف الصراع العالمي التي جاء فيها، تمثل منطلقاً واقعياً للحديث عن مسؤولية مختبرات خَاصَّة بصناعة الأوبئة لأهداف سياسيّة واقتصادية وعسكريّة.
وباءٌ من صنع البشر لا من صنع الطبيعة
في خطابه الأخير، تناول قائد الثورة السيد عَبدالملك بدرالدين الحوثي، موضوعَ “كورونا” من هذه الزاوية، مقدماً في البداية قاعدةً عامةً تفيدُ بأن تصرفات البشر هي سبب انتشار أي وباء، ويتفرع من هذه القاعدة فرعان، الأول أن يكون الوباء ناتجاً عن خلل بشري في التعامل مع الطبيعة، أي بدون قصد الوصول إلى نشرِ مرضٍ ما، والثاني هو تعمد صناعة الوباء والمرض للإضرار بالناس في إطار صراع معين، وهو ما يسمى “الحرب البيولوجية”، وفي المتناول تقديم شواهد كثيرة على الفرعين، لكن الفرع الثاني هو الأكثر حضورا اليوم لعدة أسباب.
لن يكونَ من المبالغة القول: إن الثورة الصناعية اللامحدودة التي يشهدها العالم منذ عقود، لم تترك مجالا للكوارث الوبائية غير المقصودة، ذلك أن هذه الثورة ارتبطت بسباق سياسيّ واقتصادي وعسكريّ أبرز مميزاته هو التجرد التام من كُـلّ الجوانب أخلاقية، وقد شهد العالم كله على نتائج استخدام التطور الصناعي في هذا السباق من خلال الحروب العالمية وغير العالمية التي تفننت الدول المتطورة خلالها في استخدام كُـلّ ما يمكنها من وسائل القتل لخدمة السياسة والاقتصاد بدون أية مراعاة لأي شيء آخر، واسألوا “هيروشيما” عن ذلك.
ولعل ما نشاهده نحن اليوم من إصرار دول الغرب على الاستمرار ببيع الأسلحة (وضمنها الأسلحة المحرمة دولياً) لتحالف العدوان على اليمن رغم كُـلّ جرائمها المشهودة، هو دليلٌ واضح على أن المصلحة الاقتصادية للوبي المصنع للأسلحة في دول العالم، تتجاوزُ كُـلَّ القيم والقوانين و”حقوق الإنسان” وبشكل علني، وعلى هذا يمكن قياس الحرب البيولوجية التي ثبت بالفعل استخدامها بنفس الطريقة ولذات المصلحة.
محطاتٌ من تأريخ الحروب البيولوجية
ترجع المصادرُ التاريخية بدايات الحروب البيولوجية إلى عصور قديمة جِـدًّا، وهو ما يعني أن امتلاك السلاح البيولوجي وبالذات بالنسبة إلى الدول الاستعمارية قد مثّل أهميّةً لا تقل عن أهميّة امتلاك السلاح الناري، وقد استخدم البريطانيون السلاحَ البيولوجي مع بدايات وصولهم للقارة الأمريكية، في إطار جرائمهم ضد سكانها الأصليين (الهنود الحمر)، حَيْــثُ تؤكّـد المراجع أنه في القرن الثامن عشر قامت القوات البريطانية بإرسال ملابسَ ملوثة بمرض الجدري للسكان المحليين في أوهايو وبنسلفانيا، ما أَدَّى إلى مقتل أكثرَ من نصفهم.
وشهدت الحربان العالميتان الأولى والثانية فضائحَ وتبادُلَ اتّهامات بين الدول المتحاربة باستخدام “الطاعون والكوليرا” كأسلحة بيولوجية.
وتصدرت بريطانيا وأمريكا المشهدَ في الحرب العالمية الثانية بواحد من أخطر الأسلحة البيولوجية على الإطلاق، وهو ما يسمى “الجمرة الخبيثة” الذي كانت الدولتان تخططان لصنع قنابل منه بوزن (200 كيلو غرام) لإلقائها على البلدان المعادية، وقد أجرت بريطانيا تجارب على هذا الوباء في جزيرة غرونارد التي ما زال دخولُها محرماً على البشر والحيوانات حتى اليوم؛ بسَببِ تلوثها بالكامل، وفي الفترة ذاتها، بدأت الولاياتُ المتحدة مشروع أبحاث في مريلاند، لنفس الغرض، وما زالت تحتفظ به “لأسباب دفاعية”!
وفي عام 1952 اتهم فريقٌ من الخبراء الدوليين الولايات المتحدة بأنها تستخدم أسلحةً بيولوجية في حربها مع كوريا الشمالية، وبعدها بثلاث سنوات، عام 1955، قامت أمريكا بإنتاج كميات كبيرة من بكتيريا “التلريات” التي تُصيبُ القوارض وتُعدِي البشر، وذلك في موقع “باين بلف” بولاية أركنساس، وهو الموقع الذي أصبح بعدها بسنة واحدة مستودعا رسميا لمختلف الأسلحة البيولوجية الأمريكية.
وقد حاولت الولايات المتحدة عام 1955 نفسه، أن تتهرَّبَ من الفضيحة، وقامت بوضع قائمة تضمن 17 دولة اتهمتها بإنتاج وتصنيع أسلحة بيولوجية، وبالطبع لم يكن اسم أمريكا في تلك القائمة؛ لأَنَّها وضعتها لتقولَ أصلاً إنها الدولُ الوحيدة البريئة في العالم!
وعام 1960، تم اتّهام الولايات المتحدة أَيْـضاً باستخدام أسل عَاماً حة بيولوجية في الحرب على فيتنام، وكان موقع “باين بلف” لا زال يُستخدَمُ كمستودع للأسلحة البيولوجية الأمريكية وقتها، إذ لم يعلن عن إغلاقُه إلا بعد 12 عَاماً.
وفي 2008، اتهم رئيس زيمبابوي الحكومةَ البريطانية باستخدام الكوليرا كسلاح بيولوجي أَدَّى إلى مقتل مئات الأشخاص؛ مِن أجلِ إسقاط النظام.
هذه مُجَـرّد أمثلة بسيطة من التاريخ المعروف للجميع، والذي تمتلك فيه الولايات المتحدة وبريطانيا فيه جزءاً واسعا جِـدًّا من فضائح استخدام الأوبئة والأمراض كأسلحة بيولوجية لاستهداف الدول المعادية لهما.
وفي اليمن رأينا خلال السنوات الخمس الماضية كيف تفشت الكثير من الأوبئة والفيروسات التي قتلت أعداداً كبيرة جِـدًّا من المواطنين، وبالرغم من أن المنظماتِ الدوليةَ ظلت تبرّر هذه الأمراض بالظروف الصعبة التي خلقتها الحرب، إلا أن تلك المنظمات لم تستطع حتى الآن أن تبرّر تزايد حالات التشوه التي أُصيب بها أجنة في بطون أمهاتهم.
وقد نشرت وكالة (DW) الألمانية عام 2016، تحقيقاً طرحت فيه تساؤلاتٍ مهمةً حول حالات تشوه الأجنة في اليمن، وبيّن التحقيق أنه بالرغم من أن هذه الحالات يمكنُ أن تحدثَ لعدة أسبابٍ في الظروف الطبيعية، إلا أنها تزايدت بشكل ملحوظ منذ بدء العدوان، الأمر الذي يشيرُ بالتأكيد إلى سببٍ آخرَ متعلقٍ بالحرب، وقد تساءل التحقيق إذَا ما كان لهذا السبب علاقة باتّهامات منظمتَي “رايتس ووتش” و”العفو الدولية” لتحالف العدوان باستخدام أسلحة محرَّمة دولياً في اليمن، وهي بالمناسبة أسلحة أمريكية وبريطانية أَيْـضاً.
لماذا لا نستبعد تورُّطَ أمريكا في صناعة “كورونا”؟
إن المحطاتِ المذكورةَ سلفاً تكفي للتأكّـد بأن الدول المتطورة وعلى رأسها الولايات المتحدة، قد حرصت منذ وقت مبكر على امتلاك أشد الأسلحة البيولوجية فتكاً، وهي بالطبع لم تمتلكها؛ مِن أجلِ متعة امتلاكها فقط، بل استخدمتها في إطار حروبها الوحشية لخدمة أهدافها السياسيّة والاقتصادية، بدون النظر إلى أية معايير أخلاقية.
مع ذلك، وبالعودة إلى “كورونا”، لا يزال البعضُ يتمسك بنفي أية احتمالية لتورط الولايات المتحدة أَو دول الغرب في إنتاج الفيروس ونشره، متجاهلاً ظروفَ الصراع العالمي المحتدم حالياً وبالذات بين الولايات المتحدة والصين، ويجادل هؤلاء بأن الولايات المتحدة لا يمكن أن تقوم باستهداف مواطنيها، بالنظر إلى أن الفيروس قد وصل إلى الأراضي الأمريكية.
في هذه الجزئية يشيرُ السيد عَبدالملك الحوثي إلى أن المصلحةَ الاقتصادية للّوبي الصهيوني المتواجد في أمريكا (وهو رأس المال المتحكم بأمريكا) تكفي لدفع هذا اللوبي إلى صنع ونشر أي وباء، كمقدمة لبيع لقاح له بأموال كبيرة، ولن تلتفت الشركات الصهيونية والأمريكية إلى أية اعتبارات أُخرى، والحقيقة أن هذا النوعَ من الاستغلال بات سلوكاً اقتصادية معروفاً للرأسمالية العالمية بشكل عام.
لكن حتى إذَا لم تفلح كُـلُّ شواهدِ الحروب البيولوجية في التأكيد على ذلك، فَإنَّ هناك شواهدَ أُخرى تؤكّـدُ أن شركات السلاح الأمريكية لم تتورع حتى في استخدام أمريكيين كفئرانِ تجارِبَ على عقاقيرَ وموادٍّ كيمائية ذات تأثير خطير جِـدًّا على البشر، وكان الهدف عسكريًّا، وبالتالي اقتصادياً بالضرورة.
يحكي الفيلم الأمريكي “سلّم يعقوب” الذي أنتج عام 1990 قِصةً عن جندي أمريكي نجا من حادثة غريبة أثناء مشاركته في فيتنام، حَيْــثُ قام الجيش بتجريب عقار كيميائي على الكتيبة التي ينتمي إليها هذا الجندي؛ بغرض تحويلهم إلى آلات قتل لا ترحم ولا تتراجع، لكن الأثر كان عكسياً، حَيْــثُ قام أفراد الكتيبة بمهاجمة بعضهم بطريقة وحشية جِـدًّا، ما أَدَّى إلى مقتل الكثير منهم.
بالرغم أن الفيلم لم يُقتبس، رسمياً، عن قصة حقيقية، إلا أنه لفت الانتباهَ وقتَها إلى كواليسَ مهمةٍ.
وفي مارس 2012، نشرت شبكة “سي إن إن” الأمريكية، تحقيقاً تضمَّن قصصَ جنود أمريكيين تعرضوا لتجاربَ مخبرية مماثلة نفّــذها الجيش الأمريكي، خلال فترة الحرب على فيتنام، ونقلت الشبكة عن وثائق سرية أنه: “من عام 1955 إلى عام 1975، لم يكن الباحثون العسكريّون في إدجوود أرسنال يستخدمون الحيوانات فحسب، بل الأشخاص من البشر لاختبار الأدوية والمواد الكيميائية والتي تضمنت غازات الأعصاب القاتلة المحتملة مثل VX، والسارين، ومواد أُخرى مثبطة مثل BZ” (عقار يسبب مضاعفات خطيرة جِـدًّا على الإنسان منها الهلوسات والهياج وقد يتطور إلى الفشل الكلوي)
وقالت التحقيق، ووِفْــقاً لوثائق، إن برنامج الأبحاث السري هذا كان مختصاً بدراسة أسلحة كيميائية هجومية ودفاعية، كانت الولايات المتحدة تسعى لتصنيعها، ووِفْــقاً لفيديو مصور قالت الشبكة إنها حصلت عليه، يقول أحد القائمين على المشروع إنه بإمْكَان نشر هذه المواد الكيميائية عبر “الذخائر العادية”.
وتضمّن التحقيقُ حقائقَ كثيرةً عن هذه التجارب، وشهادات وعلى لسان بعض من تعرضوا لها، وكلها تؤكّـد إجمالاً على أن الولايات المتحدة قد سبق وجعلت مصلحتها السياسيّة والاقتصادية فوق كُـلّ الاعتبارات الأخلاقية وحتى “الوطنية” بما في ذلك سلامة أفراد الجيش الأمريكي أنفسهم.
ووِفْــقاً لذلك فَإنَّ محاولة تبرئة الولايات المتحدة اليوم من احتمالية استخدامها “كورونا” كسلاح بيولوجي، والمجادلة بأنها “لن تخاطر بسلامة مواطنيها”، أمر لا أَسَاس له، فالولايات المتحدة التي يعرف الجميع أن الشركات الكبرى هي من ترسم كُـلّ سياساتها، قد قدمت خلال العقود الماضية الكثير من الأدلة المسبقة على أنها لا تقيم وزنا لأي شيء، وأن مصالح هذه الشركات هي المعيار الأول والأخير للسياسة الأمريكية.